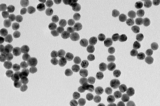

July, 2024
-
31 July
Hạt nano vàng có thể thay thế kháng sinh
Điều gì sẽ xảy ra nếu bạn có thể sử dụng một thanh kiếm laze để chống lại những kẻ xâm lược vô cùng nhỏ, không phải ở một thiên hà xa xôi mà là trong chính cơ thể bạn? Các nhà khoa học đã phát triển một kỹ thuật dùng các hạt nano vàng được làm nóng…
-
8 June
Nghiên cứu khám phá tác nhân gây lão hóa tế bào: ‘Hy vọng về sự trường thọ khỏe mạnh’
Trước đây, tổn thương cơ học ở màng tế bào được cho là nguyên nhân giúp tế bào phục hồi hoặc chết. Nghiên cứu mới cho thấy kết quả thứ 3: lão hóa tế bào.